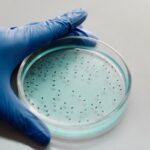
Βακτήρια που προκαλούν την σπάνια αλλά θανατηφόρα λοίμωξη Μελιοείδωση εντοπίστηκαν στον Μισισιπή

Τα τέσσερα λάθη που πρέπει να αποφεύγουμε στο πλύσιμο των πιάτων.
Έξι εβδομάδες νωρίτερα από ό,τι συνήθως εμφανίστηκε ο ιός της γρίπης στις Ηνωμένες Πολιτείες, με υψηλά ποσοστά νόσησης. Απαραίτητος ο εμβολιασμός σύμφωνα με τα Κέντρα Ελέγχου και Πρόληψης Ασθενειών της Αμερικής.
Οι ερευνητές επισημαίνουν ότι όσο αυξάνεται το προσδόκιμο ζωής στις ανεπτυγμένες χώρες, γίνεται ολοένα πιο συχνή η ζωή με πολλαπλά προβλήματα υγείας, ιδίως αν συνυπάρχει έλλειψη ύπνου.
Διπλάσιο ποσοστό σε σχέση με τον μέσο όρο της ΕΕ, σύμφωνα με τη Eurostat.
Ο Σύλλογος Οροθετικών Ελλάδας «Θετική Φωνή» εξέφρασε τη βαθύτατη ικανοποίηση του για την εξέλιξη.
Η πανδημία έφερε αλλαγές στις προσωπικότητες των ανθρώπων.
Με ανακοίνωσή του το υπουργεία Υγείας ενημερώνει ότι έχουν παραληφθεί στη χώρα μας τα επικαιροποιημένα εμβόλια Pfizer BA 4/5.
Ερευνητές αξιολόγησαν τις διατροφικές συνήθειες ενηλίκων και παιδιών σε 185 χώρες.
Πότε και ποιοι πρέπει να την κάνουν.
Ο χρονισμός του φαγητού φαίνεται ότι παίζει ρόλο και στην ψυχική κατάσταση του ανθρώπου, σύμφωνα με αμερικανική επιστημονική έρευνα.
Τι ισχύει για τα πιστοποιητικά εμβολιασμού.
Οι ερευνητές τόνισαν την ανάγκη να μελετηθεί περαιτέρω πόσο και πώς η ευλογιά των πιθήκων μπορεί να επηρεάσει τον εγκέφαλο.
Καταγραφή αυξημένου αριθμού περιστατικών λοίμωξης από τον ιό του Δυτικού Νείλου αναφέρει ο ΕΟΔΥ ο οποίος συστήνει εκ νέου να λαμβάνονται με ιδιαίτερη συνέπεια μέτρα προφύλαξης από τα τσιμπήματα κουνουπιών.
Ασυνήθιστα αυξημένη η διασπορά της γρίπης.
Ανοίγει σήμερα το απόγευμα, η πλατφόρμα για την εγγραφή των πολιτών στο θεσμό του προσωπικού γιατρού που έχουν συμπληρώσει το 16ο έτος της ηλικίας τους και στις Περιφέρειες Αττικής και Νοτίου Αιγαίου.
Πέντε νέα περιστατικά οξείας ηπατίτιδας άγνωστης αιτιολογίας καταγράφηκαν στη χώρα μας τις τελευταίες είκοσι ημέρες.
Σύμφωνα με Νορβηγούς επιστήμονες.
Στους 117 διασωληνωμένοι.
Τι δείχνει η νέα μελέτη του Πανεπιστημίου της Καλιφόρνιας-Μπέρκλεϊ για τις επιπτώσεις της έλλειψης ύπνου.
Σύμφωνα με βρετανική έρευνα.
Δείτε σε ποιους μπορεί να χορηγηθεί.
Τα συμπτώματα της μελιοείδωσης περιλαμβάνουν πυρετό, πόνο στις αρθρώσεις και πονοκέφαλο.
Ποιοι πρέπει να κάνουν τέταρτη δόση και πότε, σύμφωνα με επίσημη σύσταση που εξέδωσε το Ευρωπαϊκό Κέντρο Πρόληψης και Ελέγχου Νοσημάτων και ο Ευρωπαϊκός Οργανισμός Φαρμάκων.
Ο ΕΟΔΥ ανακοίνωσε τον πρώτο θάνατο παιδιού στην Ελλάδα, που συνδέεται με οξεία ηπατίτιδα άγνωστης αιτιολογίας και πρόκειται για ένα βρέφος 13 μηνών.
Οι αμερικανικές πολιτείες, που έχουν νομιμοποιήσει τη χρήση κάνναβης, εμφανίζονται να καταγράφουν αύξηση της τακτικής χρήσης της, ενώ και τα lockdown εξαιτίας της COVID είχαν παρόμοιο αποτέλεσμα, σύμφωνα με σημερινή αναφορά του ΟΗΕ.
Για τους 30 - 59 ετών.
Ο επικεφαλής του Τμήματος Ιολογίας του Πανεπιστημιακού Νοσοκομείου Charité στο Βερολίνο, Κρίστιαν Ντρόστεν, έκρουσε τον κώδωνα του κινδύνου για νέο κύμα της πανδημίας Covid-19 από το φθινόπωρο.
Ο οργανισμός εξετάζει πληροφορίες για την παρουσία του ιού στο σπέρμα ασθενών.